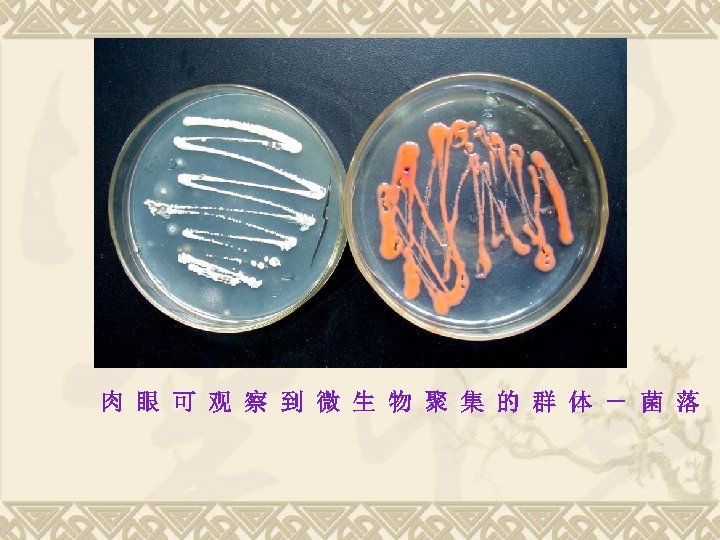
肉 眼 可 观 察 到 微 生 物 聚 集 的 群 体

372a0be17655e58d4e4fb6fd95ea4217.ppt
- Количество слайдов: 65

兽医微生物学

绪 论 1、什么是微生物 2、微生物在生物界的位置 3、微生物的五大共性 4、微生物与人类的关系 5、微生物学的发展 6、微生物学及其分科 7、微生物学对生命科学的贡献 8、21世纪微生物学的展望 五、 绪 论

一、什么是微生物 微生物(microorganism,microbe): 存在于自然界中的一类体积微小,构造简单,繁 殖快,分布广,肉眼直接看不到,必须借助于光学显 微镜或电子显微镜放大数百倍、数千倍甚至数万倍才 能看到的微小生物。

(一)微生物的特点 1、小 个体微小 μm级: 光学显微镜可见(细胞); nm级: 电子显微镜下可见(细胞器、病毒)。 2、简 构造简单 单细胞、简单多细胞、非细胞(分子生物)。 3、低 进化地位低
肉 眼 可 观 察 到 微 生 物 聚 集 的 群 体 - 菌 落

(二)微生物的种类 按其结构、组成等的差异分为: v 非细胞型微生物:病毒、类病毒、拟病毒等; v 原核细胞型微生物:细菌、放线菌、蓝细菌、 立克次氏体、衣原体、支原体、螺旋体等, v 真核细胞型微生物:真菌(酵母菌、霉菌和蕈 菌)、单细胞藻类、原生动物等。

二、微生物在生物界的位置 (一)生物的界级分类学说 (二)分类单位与命名

(一)生物的界级分类学说 随着人们对微生物认识的逐步深化,近一百多 年来,从两界系统经历过三界系统、四界系统、五界 系统甚至六界系统,最后又出现了三原界(或三总界) 系统。 图 生物界级学说的发展(阴影部分为微生物)

1、二界系统 动物界、植物界。 人们对于动植物形态和类别的认识有了一些系 统的知识。 我国春秋时期已形成了对生物分成动物和植物 两大类的认识(《周礼·地官》、《考 记》等著作 中),这就是最早的“二界系统”。 于公元前4世纪时亚里斯多德也提出了生物可分 为动物和植物的“两界系统”。 对两界系统较为科学的叙述是 1753年瑞典博物 学家林奈在《植物种志》中提出来的。

2、三界系统 德国动物学家E.N.Haeckel(1866)提出: 动物界、植物界、原生生物界(Protista)。 原生生物界主要由一些单细胞生物及“无核类” (Monera)生物组成,包括细菌、藻类、 真菌和原生动物。

3、四界系统 1938年Copeland提出四界,1956年成熟: 植物界; 动物界 原生动物除外; 原始生物界 包括原生动物、真菌、部分藻类; 菌界----原核生物界(Monera) 包括细菌、蓝细菌。

4、五界系统 1969年Whittaker提出了五界学说,五界系统包括: 动物界(Animalia); 植物界(Plantae); 原生生物界(Protista) 包括原生动物、单细胞藻类、 粘菌等; 真菌界(Fungi) 包括真菌和酵母菌; 原核生物界(Monera)包括细菌、蓝细菌等。

图 Whittaker的五界系统示意图 以纵向显示从原核生物到真核单细胞生物再到真核多细胞生物的三大进化阶段, 而以横向显示光合营养(photosynthesis)、吸收式营养(absorption)和摄食 式营养(ingestion)这三大进化方向。

5、六界系统 我国学者王大耜等(1977)在Whittaker五 界系统的基础上,也提出过应增加一个病毒界( Vira)的六界系统: 动物界;植物界;原生生物界;真菌界; 原核 生物界; 病毒界。 1996年美国P. H. Raven等的六界系统: 动物界;植物界;原生生物界;真菌界; 真细 菌界; 古细菌界。

6、三总界五界系统 我国学者陈世骧(1979年)等按生物历史发展的三 个阶段的不同将生物分为来分三个总界,再按生理、 生态特性的差别分五个界。 Ⅰ.非细胞总界(Superkingdom. Acytonia) Ⅱ.原核总界(Superkingdom. Procaryota) 1.细菌界(Kingdom. Mycomonera) 2.蓝细菌界(Kingdom. Phycomonera) Ⅲ.真核总界(Superkingdom. Eucaryota) 3.植物界(Kingdom. Plantae) 4.真菌界(Kingdom. Fungi) 5.动物界(Kingdom. Animalia)

7、三原界系统 根据 16 Sr. RNA核苷酸顺序的同源性测定,1978年R.H. Whittaker和L.Margulis提出了三原界(Urkingdom)学说。在 生物进化过程的早期,存在着一类各生物的共同祖先,由它分三 条进化路线,亦即形成了三个原界: ①古细菌(Archaebacteria)原界 包括产甲烷菌,极端嗜盐菌和嗜热嗜酸菌; ②真细菌(Eubacteria)原界 包括蓝细菌和各种除古细菌以外的其他原核生物; ③真核生物(Eucaryotes)原界 包括原生生物、真菌、动物和植物。

图 三原界系统图示

(二)分类单位与命名 1、分类单位 界,门,纲,目,科,属,种。 种是最基本的分类单位, 它是一大群表型特征高度 相似,亲缘关系极其相近,与同属内其它种有着明显 差异的菌株的总称。 种以下又分亚种(变种),型,类群,菌株(品系)。

2、命名 按照《国际细菌命名法规》,采用林奈氏双名法。 属名 + 种名 +命名人 属名:名词,斜体,首字母大写,一般描绘主要形 态或生理特征。 种名:形容词,斜体,小写,代表一个种次要特征。 如大肠杆菌: Escherichia coli (Migula) Castellani & Chalmers 1919 E. coli(Escherichia coli 大肠埃希氏菌,简称大肠杆菌) 未确定种名或不指特定的种时,可在属名后加sp. 表示,如 Penicillium sp. (青霉属)。

三、微生物的五大共性 1、体积小、面积大 2、吸收多、转化快 3、生长旺、繁殖快 4、适应强、易变异 5、分布广、种类多

(一) 体积小、面积大 病毒——﹤ 0. 2 m 杆状细菌—— 0. 5× 2. 0 m 支原体 立克次氏体 衣原体 } 0. 2~ 0. 5 m 放线菌——菌丝直径﹤ 1 m 霉菌——菌丝直径 2~ 10 m 酵母—— 1~ 5× 5~ 30 m

比面值 = 表面积/体积﹦ 4 π r 2/4/3 πr 3 =3/r 个体微小,其体积必然很小。一个典型的球菌 体积仅1μm 3,每个球菌都有其相应的表面,它所拥 有的表面积要比同体积其他生物所拥有的表面积大 得多。因此说,微生物体积小、面积大。 这是微生物五大共性的基础,由它可发展出一 系列其他共性。

(二) 吸收多,转化快 微生物对于营养物质的吸收和代谢产物的排出都 是通过细胞表面进行的,因此体积小、面积大就为其 提供一个巨大的营养物质吸收面和对于外界环境信息 的接收面。吸收多就转化快。 3克地鼠每天消耗与体重等重的粮食; 1克闪绿蜂鸟每天消耗两倍于体重的粮食; 大肠杆菌每小时消耗 2000倍于体重的糖。

发酵乳糖的细菌在 1小时内就可以分解相当于其 自身重量 1, 000~10, 000倍的乳糖,产生乳酸; 1公斤酵母菌体,在一天内可发酵几千公斤的糖, 生成酒精; 微生物的这个特性为它们的高速生长繁殖提 供了物质基础。人类利用微生物生产许多产品, 就是因为它们的生物化学转化能力特别强——“ 活的化 厂”。

(三) 生长旺,繁殖快 由于其吸收多、转化快,因此具极高的生长和繁殖速度。 例如:Escherichia coli (大肠杆菌)在最适的生长条件 下,每 12. 5~20分钟细胞就能分裂一次。24 h其后代 4722 366 500万亿个,重约 4722吨。 500 kg酵母菌以废糖蜜和氨水为养料,24 hr可合成 5000 kg优良蛋白质。 微生物的这一重要特性在发酵 业中具有重要的实 践意义,可使发酵周期缩短,生产速率提高。 但若是有害微生物,将会给人类带来极大的损失和 危害。

表 1-3 若干微生物的代时及每日增殖率 微生物名称 代时 每日分裂次数 温度 每日增殖率 乳酸菌 38分 38 25 2. 7× 1011 大肠杆菌 18分 80 37 1. 2× 1024 根瘤菌 110分 13 25 8. 2× 103 枯草杆菌 31分 46 30 7. 0× 1013 光合细菌 144分 10 30 1. 0× 103 酿酒酵母 120分 12 30 4. 1× 103 小球藻 7小时 3. 4 25 10. 6 念珠藻 * 23小时 1. 04 25 2. 1 硅藻 17小时 1. 4 20 2. 64 草履虫 10. 4小时 2. 3 26 4. 92 * 为念珠蓝菌属 (Nostoc) 的旧称,与细菌同属原核生物。

(四)适应强、易变异 1、适应强 微生物具有极其灵活的适应性或代谢调控机制, 这是任何高等动、植物无法比拟的。微生物 对环境条件尤其是地球上的极端环境有极其惊人的 适应能力,堪称“生物界之最”。 ★任何有其它生物生存的环境中,都能找到微生物。 而在其它生物不可能生存的极端环境中也有微生物 存在。

2、易变异 微生物一般都是单细胞、简单多细胞或非细胞的, 通常都是单倍体(n),容易发生变异(变异频率十分 低10 -5 ~ 10 -10)。最常见的变异形式是基因突变。 微生物的变异有:有益变异和有害变异。 ★ 突变频率虽低,但因繁殖快,数量多,与外界 环境直接接触,因而在短时间内可出现大量变异的 后代。

(五)分布广、种类多 1、分布广 微生物因其体积小、重量轻,可以随空气流动 到处传播。但其怕明火,地球上除了火山的中心区 域外,到处都有微生物的踪迹。 万米深海、85公里高空、 地层下128米和427米 沉 积岩中都发现有微生物存在。

2、种类多 (1) 物种的多样性 (2) 生理代谢类型的多样性 (3) 代谢产物的多样性 (4) 遗传基因的多样性 (5) 生态类型的多样性

微生物的“生物界之最” 个体最小 数量最多 分布最广 变异最易 起源最早 ‘胃口’最大 抗性最强 发现最晚 食谱最广 休眠最长 界级最宽 繁殖最快 种类最多 形态最简

四、 微生物与人类的关系 (一) 害 在人类历史上微生物给人类带来很多大灾难。 (二) 益 微生物对于人类“益大于害”,生产、生活都离不开微 生物。 (三) 微生物的应用 微生物的生理及代谢类型多种多样、代谢活力强、代 谢产物多种多样,已广泛应用于 农业生产、医药卫 生、环境保护等方面。

1、 业 通过微生物的 业化培养,为人类生产出多种 产品。 (1) 食品(发酵食品、食品添加剂、调料等) (2) 化 (酶制剂、氨基酸、有机酸、新材料 开发等生物化 ) (3) 能源开发(如沼气发酵、石油发酵、产氢 发酵)

酸酸的食物 v v v 食物变酸后,有的能吃,有的不能吃。 有些酸酸的食物是人类利用微生物制造出来的 利用显微镜可以观察到发酵食物中的微生物 人们利用微生物制造出来的食物很多,如 酒 面包 馒头 泡菜 豆腐乳

2、农业 微生物在当代农业生产中具有十分显著的作用。 (1) 农药(农用抗菌素、微生物生物农药防治害虫、 防治有害微生物、农作物有害植物等) (2) 肥料(堆肥、厩肥、固氮作用的菌肥) (3) 植物生长刺激素(赤霉素—— 920) (4) 饲料(微生物分解有机物质、菌体蛋白——SCP, single cell protein) (5) 畜用生物制品(免疫制剂、药剂) (6) 微生物能源——沼气发酵 (7) 食用、药用真菌

3、医药卫生 (1)医药 抗生素、免疫制品、生物药品、药用真菌等,用“ 程菌”生产药物(脑菲肽、胰岛素、干扰素等)。 (2)消毒灭菌 利用物理或化学方法杀灭物品上病原微生物或全部 微生物。 4、环境保护 目前,在污水处理中,微生物起着重要作用,有的 固体废弃物也可用微生物处理。

5、生物 程学(生物技术) 以生物学的理论和技术为基础(特别是其中的微 生物学、遗传学、生物化学和细胞学),结合化 、 机械、电子计算机等现代 程技术,充分运用分子生 物学的最新成就,自觉地操纵遗传物质,定向地改造 生物或其功能,短期内创造出具有超远缘性状的新物 种。再通过合适的生物反应器,对这类“ 程菌”或“ 程细胞株”进行大规模的培养。以产生大量有用代谢产 物或发挥它们独特生理功能的一门新兴技术。

常规菌(或常规细胞株) ①遗传 程 改造物种 ② 细胞 程 “ 程菌”(或“ 程细胞株”) 生物 程 ③ 微生物 程 ④ 酶 程 商品生产 ⑤ 生物反应器 程 经济效益 大量产品 社会效益 生态效益

微生物 程的内容 微生物菌体生产和应用 微生物代谢产物的应用 微生物机能的利用

五、微生物学发展简史 人类认识微生物的四个障碍: ①个体过于微小 ②群体外貌不详 ③种间杂居混生 ④形态与其作用后果之间很难被人认识

微生物学发展的五个时期 1、史前期 2、初创期 3、奠基期 4、发展期 5、成熟期

(一)史前期(约 8000年前 ~ 1676) 各国劳动人民,其中尤以我国的制曲、酿酒 技术著称 远古人类发现,吃剩的米粥数日后变成 了醇香可口的饮料—人类最早发明的酒

我国古代的酿酒作坊 (四川新都县出土的汉代画像)

殷 商 酒 具

公元前2300年左右,埃及人酿制啤酒的场面

Anthnoy van Leeuwenhoek与他的显微镜 Leeuwenhoek 1684年寄给皇家协会信的部分内容

(三)奠基期(1861 ~ 1897) 生理水平研究阶段(巴斯德、科赫) 1、微生物学开始建立 2、创立了一整套独特的微生物学基本研究方法 3、开始运用“实践-理论-实践的思想方法开展 研究 4、 建立了许多应用性分支学科 5、进入寻找人类和动物病原菌的黄金时代

Louis Pasteur (1822 – 1895) 1、解决了当时 、农、医方面提 出的许多难题,推动了生产的发展: 2、彻底否定了生命“自然发生”学说; 3、奠定了微生物学的理论基础; 4、创造了一些微生物学实验方法; 5、证实发酵是由微生物引起的; 6、免疫学—预防接种; 7、发明巴氏消毒法( Pasteurization)

巴斯德的雁颈瓶——曲颈瓶实验

Robert Kock (1843 – 1910) 1、发明了固体培养基,提出了 微生物纯培养的概念和方法; 2、创造了细菌染色的方法; 3、发现了许多病原菌,如炭疽 杆菌、结核杆菌、霍乱弧菌等; 4、证明某种微生物是否为某种 疾病病原体的基本原则——柯赫原则

柯赫原则 1) 在每一病例中都出现这种 微生物; 2) 要从寄主分离出这样的微 生物并在培养基中培养出来; 3) 用这种微生物的纯培养接 种健康而敏感的寄主,同样的 疾病会重复发生; 4) 从试验发病的寄主中能再 度分离培养出这种微生物来。

(四)发展期(1897 ~ 1953) 生化水平研究阶段(生物化学奠基人——布切诺) 1、对无细胞酵母菌”酒化酶“进行研究; 2、发现微生物的代谢统一性; 3、普通微生物学开始形成; 4、开展广泛寻找微生物的有益代谢产物; 5、青霉素的发现推动了微生物 业化培养技术的猛 进。

Alexander Fleming (1881 -1955) Alexander Fleming 1929年发现了青霉素(penicillin)—— 世界第一个抗生素

(五)成熟期(1953 ~ 至今) 分子生物学水平研究阶段 1、广泛运用分子生物学理论和现代研究方法,深刻揭示 微生物的各种生命活动规律; 2、以基因 程为主导,把传统的 业发酵提高到发酵 程新水平; 3、大量理论性、交叉性、应用性和实验性分支学 科飞速 发展; 4、微生物学的基础理论和独特实验技术推动了生命科学 各领域的飞速发展; 5、微生物基因组的研究促进了生物信息学时代的到来。

成熟期特点 微生物学成为十分热门的前沿基础学科 微生物成为生物学研究中的最主要对象 生物 程中,发酵 程是最成熟的应用技术

六、微生物学及其分科 (一)微生物学的研究内容 (二)学习微生物学的目的与任务 (三)微生物学分科

(一)微生物学的研究内容 微生物学是研究微生物及其生命活动规律的学 科,是在细胞、分子或群体水平上研究微生物生命 活动基本规律,并将其应用于 业发酵、医学卫生 和生物 程等领域的科学。

研究内容涉及微生物的: ①形态结构 ②分类鉴定 ③生长代谢 ④生长繁殖 ⑤遗传变异 ⑥生态分布 ⑦微生物对自然界、微生物各类群之间、微生 物与其他生物之间的相互影响、相互作用 ⑧微生物在 业、农业、医药卫生、环境保护 等方面的作用

(二)学习微生物学的目的与任务 学习目的:研究微生物及其生命活动规律是为了更 好地利用、控制、改造微生物,为人类服务。除了 利用其对人类的有利作用外,还包括防止、消除微 生物的有害活动或使之转害为利。 根本任务:开发、利用、改善和保护有益的微生物, 控制、消灭或改造有害微生物,为人类社会的进步 服务。

(三)微生物学分科 微生物学由于其研究任务不同,形成了一些分支学科。 1、按研究微生物的基本生命活动规律为目的分:总学科为普 通微生物学。 分学科为微生物分类学、微生物生理学、微生物遗传学、 微生物生态学、分子微生物学等。 2、按微生物应用领域来分:总学科应用微生物学。 分学科为 业微生物学、农业微生物学、医学微生物学、 药用微生物学、诊断微生物学、抗生素学、食品微生物学等。 3、按研究的微生物对象分:细菌学、真菌学(菌物学)、病 毒学、原核生物学、自养菌生物学、厌氧菌生物学等。

4、按微生物所处的生态环境分:土壤微生物学、微 生态学、海洋微生物学、环境微生物学、水微生物 学、宇宙微生物学等。 5、按学科间的交叉、融合分:化学微生物学、分析 微生物学、微生物生物 程学、微生物化学分类学、 微生物数值分类学、微生物地球化学、微生物信息 学等。 6、按实验方法、技术分:实验微生物学、微生物研 究方法等。

兽医微生物学的任务 将微生物学基础理论和技术知识应用到生产中, 充分发挥有益微生物的作用,控制有害微生物的作 用。利用微生物学与免疫学的知识和技能来诊断、 防治动物疾病和人畜共患疾病,保障人类的食品安 全与卫生、保障畜牧业生产,保障动物的健康及生 态环境免于破坏。

七、微生物学对生命科学的贡献 (一)微生物是生物学基本理论研究中的理想试验对象 (二)利用微生物作材料,证实了核酸是一切生物的遗传物质 基础 (三)微生物学是分子生物学的三大基础之一 (四)遗传学研究对象的微生物化,促进了经典遗传学发展成 分子遗传学 (五)微生物是遗传 程中的“宠儿”,是新生的生物 程的主 角 (六)微生物学中的一套独特的实验技术已逐渐扩散到一切生 命科学的研究中 总而言之,微生物学的发展促进了人类的进步。

八、21世纪微生物学的展望 (一)微生物基因组学研究将全面展开 (二)微生物生态学、环境微生物学、细胞微生物学 等将在基因组信息的基础上获得长足发展,为人类 的生存和健康发挥积极的作用 (三)微生物生命现象的特性和共性将更受到重视 (四)与其他学科实现更广泛的交叉,获得新的发展 (五)微生物产业将呈现全新的局面

主要参考书 v v 兽医细菌学 吴信法 编 兽医微生物学 陆承平(第三版) 医学微生物学 陆德源 主编(第四版) 微生物学 武汉大学、复旦大学 主编 微生物学教程 周德庆 著 v 微生物学 沈平 著 v Medical Microbiology(22 nd edition) v
372a0be17655e58d4e4fb6fd95ea4217.ppt